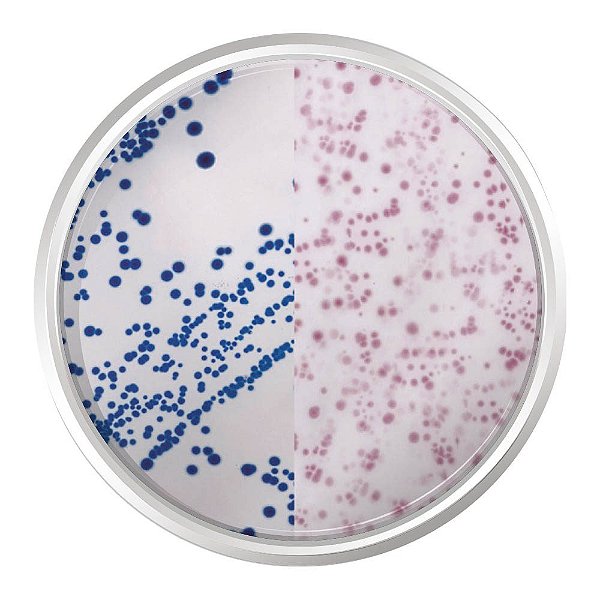
AGAR CROMOGENICO E.COLI COLIFORMES 500G - KASVI

AGAR CROMOGENICO E.COLI COLIFORMES 500G - KASVI
AGAR CROMOGÊNICO E.COLI COLIFORMES. FRASCO 500 G
Aplicação:
O Agar Cromogênico E. coli Coliformes é um meio seletivo para a detecção simultânea de Escherichia coli e outros coliformes em alimentos e água.
Preparo:
Suspender 26,4 gramas do meio em 1 litro de água destilada. Mexer bem e dissolver o meio através de aquecimento com frequente agitação. Ferver por 1 minuto até a completa dissolução. EVITAR O SUPERAQUECIMENTO.NÃO AUTOCLAVAR. Resfriar o meio a 45°C - 50°C, mexer bem e dispensar em placas de Petri. O meio preparado deve ser armazenado entre 8°C a 15°C.
Especificações Técnicas:
Composição g/L
Cloreto de Sódio 5,00
Tampão Fosfato 4,90
Peptona Bacteriológica 3,00
Piruvato de Sódio 1,00
Triptofano 1,00
Sorbitol 1,00
Mistura Cromogênica 0,36
Tergitol-7 0,10
Agar Bacteriológico 10,0
pH Final de 6,8 ± 0,2 a 25°C.
Aparência do Meio:
DESIDRATADO: Pó de cor bege, fluído e homogêneo.
PREPARADO: Âmbar.
Controle de Qualidade:
Microrganismos Crescimento Cor da Colônia
Escherichia coli ATCC 25922 Bom Azul-escuro violeta
Escherichia coli ATCC 11775 Bom Azul-escuro violeta
Citrobacter freundii ATCC 8090 Bom Salmão
Salmonella enteridis ATCC 13076 Bom Sem cor
Enterococcus faecalis ATCC 19433 Nulo -
Armazenamento:
Após aberto manter o frasco bem fechado e de cabeça para baixo evitando a hidratação. Armazenar em local seco, longe da luz e da umidade entre 2°C a 25°C.
Descarte:
O descarte deverá ser realizado de acordo com as normas nacionais e regulamentações locais em vigor.
Registro ANVISA:
Não aplicável.
Apresentação:
Frasco com 500 gramas.
MODELO: K25-1340
MARCA: KASVI
*MEIO VENDIDO SOB DEMANDA.
Sinônimos: E.coli Coliforms Chromogenic Medium.
OBS: Imagem meramente ilustrativa do resultado típico em placa
Produtos relacionados
-
 AGAR CROMOGENICO E.COLI COLIFORMES (CCA) ISO 9308-1 500G - KASVIR$ 5.223,84até 6x de R$ 870,64 sem jurosou R$ 5.119,36 via Pix
AGAR CROMOGENICO E.COLI COLIFORMES (CCA) ISO 9308-1 500G - KASVIR$ 5.223,84até 6x de R$ 870,64 sem jurosou R$ 5.119,36 via Pix -
 AGAR CROMOGENICO SALMONELLA 500G - KASVIR$ 3.739,28até 6x de R$ 623,21 sem jurosou R$ 3.664,49 via Pix
AGAR CROMOGENICO SALMONELLA 500G - KASVIR$ 3.739,28até 6x de R$ 623,21 sem jurosou R$ 3.664,49 via Pix -
 AGAR CROMOGENICO CANDIDA PLUS 500G - KASVIR$ 2.733,15até 6x de R$ 455,52 sem jurosou R$ 2.678,49 via Pix
AGAR CROMOGENICO CANDIDA PLUS 500G - KASVIR$ 2.733,15até 6x de R$ 455,52 sem jurosou R$ 2.678,49 via Pix -
 AGAR CROMOGENICO LISTERIA BASE (ISO 11290-1) 500G - KASVIR$ 1.372,70até 6x de R$ 228,78 sem jurosou R$ 1.345,25 via Pix
AGAR CROMOGENICO LISTERIA BASE (ISO 11290-1) 500G - KASVIR$ 1.372,70até 6x de R$ 228,78 sem jurosou R$ 1.345,25 via Pix
-
A Lab-Bran atua há mais de 20 anos entregando insumos com precisão, responsabilidade e documentação correta pra quem não pode errar no laboratório. Atendemos hospitais, clínicas médicas e veterinárias, universidades, laboratórios de análises, indústrias e agronegócio — com estoque técnico e emissão fiscal pronta pra cada tipo de cliente. Seja qual for sua área, se você precisa de insumos confiáveis, pode contar com a Lab-Bran.